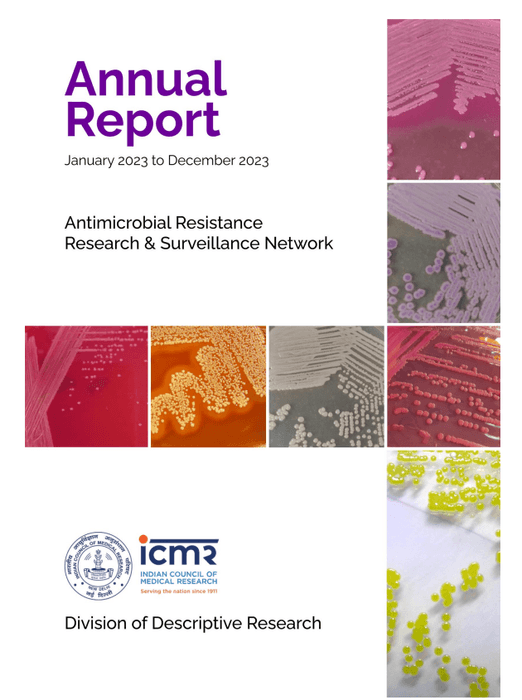
Thumbnail of www-x-com-icmrdelhi-status-1831918828441498053-918841d31951476d

Sublime
An inspiration engine for ideas

Want to make your health research more credible & impactful? Are you asking the right causal research question?
Move beyond associations — embrace causal thinking!
📢 Enroll in ICMR-NIE’s new MOOC: NIeCer 201: Causal Inference from Observational Studies... See more



The EU has found cancer-causing chemicals in 527 Indian products reaching their borders.
Last night, after an hour or two of Internet search, I believe I succeeded in finding out the likely source of that list, and what I saw is really worrying. I will share all my findings in this post, and also share the links so... See more


India allows use of #Hydroxychloroquine for high risk #COVID2019 patients. @ICMRDELHI @drharshvardhan https://t.co/FzcAx5hzYo

1/30
Our "Protein Project" report is here
What is it?
Unique public-health project funded by @paraschopra to analyze common/well-known protein supplements sold in India
Who did it?
Me & team at The Liver Institute with world class,... See more




Important Update! 🌡️🔥 Informal Workers & Heatwaves
NDMA has issued a landmark advisory to protect India’s 80% urban workforce from heatwave risks. This includes street vendors, construction workers, domestic workers & more—most exposed to rising temperatures daily. 🔥 👨🏭 1/3 https://t.co/JPm3iHWiYP
#Funding Alert!!! @DBTIndia "Emerging Frontiers in Biotechnology" initiative is inviting funding proposals under Biomedical & Biological Programs. Click here: Emerging_Frontiers_in_Biotechnology_EFB.pdf (https://t.co/sFUNsPCe9q)
@DrJitendraSingh @rajesh_gokhale https://t.co/T14ev9fxe7
Department of Biotechnologyx.com